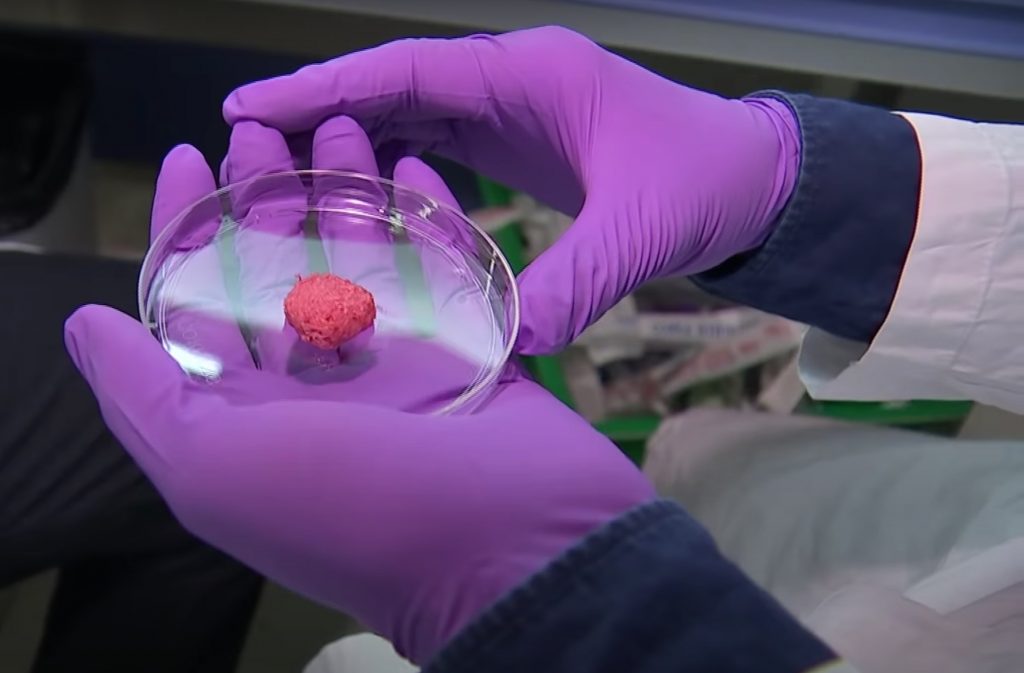

Искусственные Органы Фото
Фото Больших Сисек Толстух
Кафе Конфетти Мичуринск Фото
Доброе Утро Четверга Смешные Картинки
Самые Красивые Птицы России Фото И Названия
Фото Шпица Домашние
Сайт Который Убирает Мозаику С Фото Онлайн
Рисованные Картинки Смешные Про
Самые Обзор Фото
Американские Лошади Фото
Актриса Марго Робби Фото В Купальнике
Samsung Galaxy 6 Фото
Фото Молодежных Стрижек Для Девушек
Тойота Хайлюкс Цена Фото В России
Искусственные Органы Фото 108 фотографий